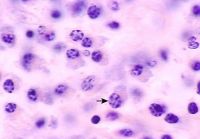
Makrofág

| 5.3.3 Imunitní systém |
|
Radiační poškození imunitního systému je vyvoláno různými mechanizmy, je však v podstatě určeno rozsahem a stupněm poškození buněk a jejich prekurzorů zodpovědných za imunitu. V závislosti na dávce ionizujícího záření se poškození buněk pohybuje od ztráty funkce až po buněčnou smrt. Rozeznáváme navozenou neschopnost dělení buněk (proliferační smrt) a bezprostřední zánik buněk (interfázová smrt). FagocytózaFagocytární systém organizmu , včetně buněk endotelu, je schopen až do dávky 10 Gy celotělového jednorázového ozáření úspěšně vychytávat cizí partikule z krevního řečiště (clearance). Je však porušena schopnost zabít a rozložit živé bakterie, což souvisí s ochromením odpovídajících nitrobuněčných enzymatických systémů a poškozením cytoskeletu. Úroveň clearance není významně snížena ani v období, kdy dochází po ozáření ke granulocytopénii až granulocytóze. MakrofágyZ monocyto-makrofágové řady jsou k ionizujícímu záření nejcitlivější dřeňové prekurzory a krevní monocyty. Jejich úbytek je zřetelný již po dávkách 2 Gy. Alveolární makrofágy jsou vůči ionizujícímu záření méně citlivé než peritoneální, tkáňové makrofágy jsou značně radiorezistentní. Ionizující záření aktivuje makrofágy podobně jako interferon γ do stavu citlivého na bakteriální lipopolysacharidy. Makrofágy aktivované interferonem γ, lipopolysacharidem nebo BCG (Bacillus Calmette-Guerin) jsou k účinkům ionizujícího záření odolnější než makrofágy klidové.
Makrofág. Vliv ionizujícího záření do dávky 10 Gy nenarušuje životnost makrofágů. Ještě 24 hodin po dávce 115 Gy je 50 % buněk živých. Radiorezistentní je i proliferace a migrace makrofágů. Podobně jako makrofágy reagují na ionizující záření i dendritické buňky (snížená životnost, prezentace antigenu), které jsou významnými pomocnými buňkami imunitního systému. NK a ADCC buňky„Zabíječské" lymfocyty definované jako NK (natural killers) nebo ADCC (antibody dependent cytotoxic cells) patří k radiorezistentní populaci imunocytů, které vykazují cytotoxicitu k cílovým buňkám i po ozáření dávkami, které se blíží letálním. Lidské NK buňky (přirození zabíječi) se charakterizují membránovým proteinem CD 16, který nesou i některé granulocyty. Malé snížení NK a ADCC aktivity, které bylo pozorováno po vysokých dávkách parciálního ozáření, se rychle upravuje do 10. dne po skončení ozáření.
NK buňky.
B-buňkyDo této buněčné řady imunocytů patří buňky, které během své diferenciace produkují imunoglobuliny jednak jako povrchové receptory pro antigen, jednak jako uvolňované protilátky. Patří sem typy nejcitlivější i nejodolnější k účinkům ionizujícího záření. Radiosenzitivní jsou pre-B-buňky a malé nezadané B-lymfocyty s membránovým receptorem IgM pro antigen. O něco odolnější jsou další aktivační stupně vývojové řady B-buněk: lymfocyty s membránovým IgD, FcR a C3R. Tyto lymfocyty se blíží svojí odolností vůči ionizujícímu záření již T-lymfocytům.
B-buňky.
|